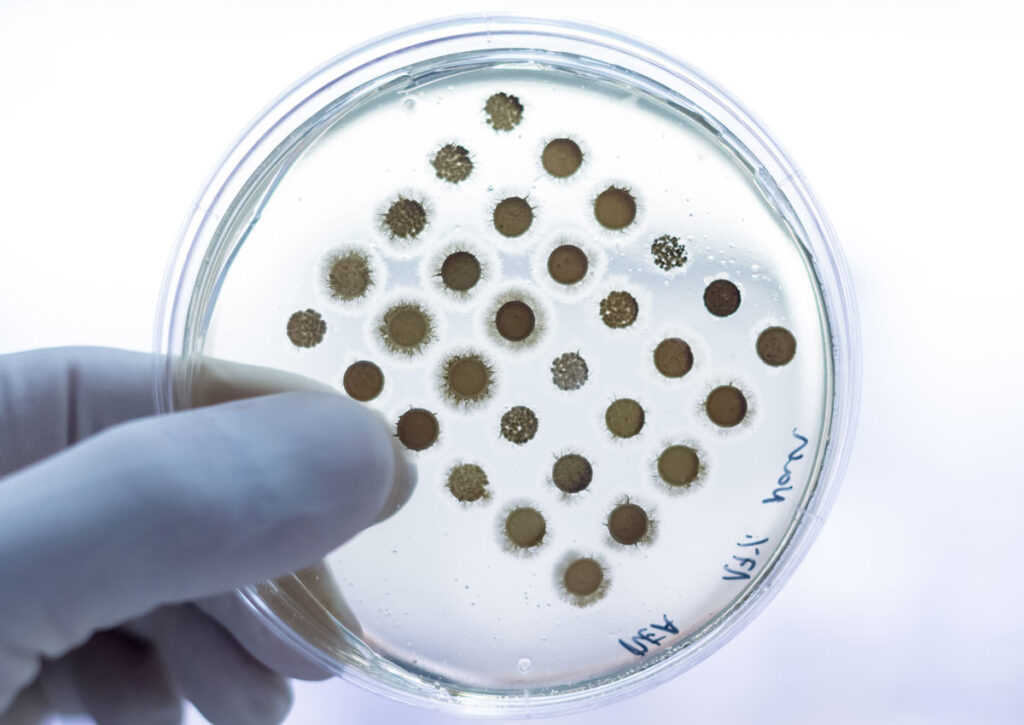

Advanced Treatment Performance

Enhances wastewater treatment efficiency in leather and tanning facilities.
Corporate Environmental Responsibility

Reinforces your brand’s commitment to sustainable and eco-conscious manufacturing.
Pollution and Odor Reduction

Reduces organic load, chemical residues, and foul odors before discharge.
Pollution and Odor Reduction

Our biotechnology provides an advanced solution for wastewater treatment in leather and tanning operations, significantly reducing organic load, chemical residues, and foul odors before discharge. By enhancing microbial activity, it optimizes existing treatment systems and accelerates the breakdown of pollutants, improving both water quality and process efficiency. The result is a cleaner, safer, and more sustainable operation that helps tanneries meet environmental regulations while demonstrating a strong commitment to responsible manufacturing.
Enhanced Biological Activity
Boosts microbial performance to accelerate the natural breakdown of pollutants.
System Optimization

Improves existing treatment infrastructure for greater reliability and output.
Discover the Eco-Friendly Solution for you Business
Let’s work together to make your facility a model of innovation, efficiency, and environmental responsibility.
Contact us today to learn how our biotechnology can help you achieve cleaner processes, lower maintenance costs, and full regulatory compliance while protecting the planet we all share.